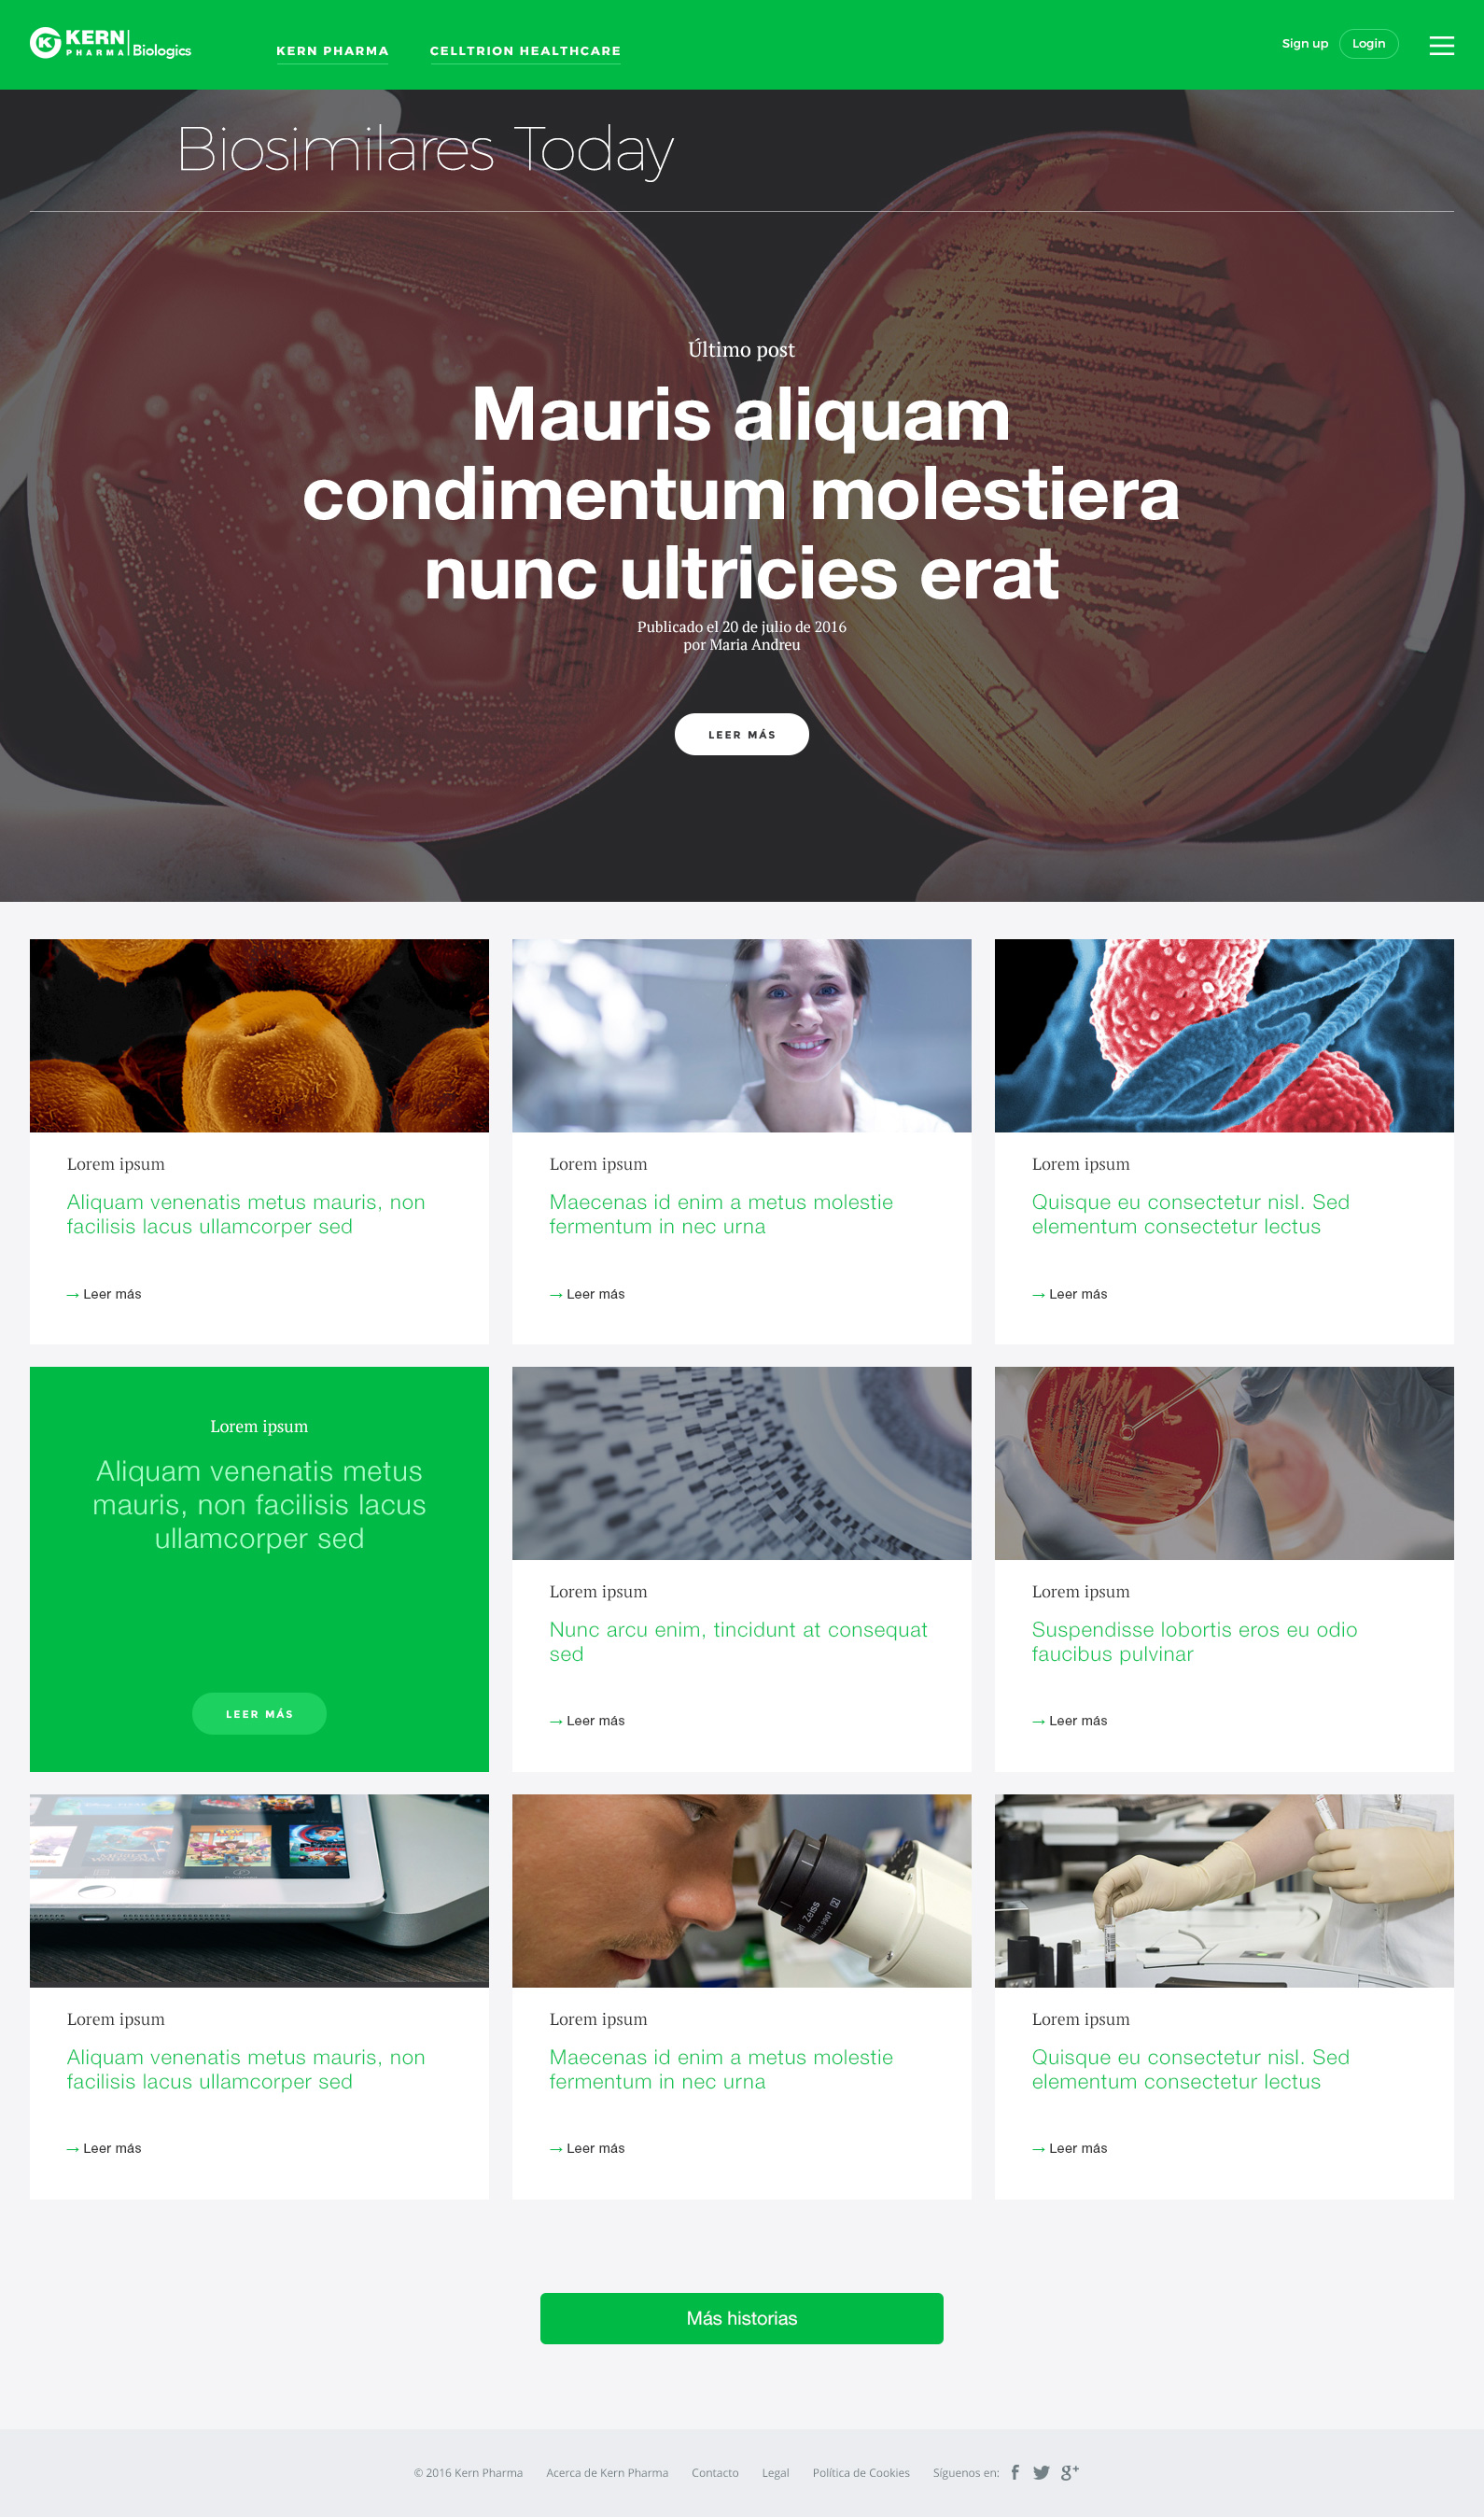

Kern Pharma Biologics
Web corporativa

El reto
Rediseñar el sitio corporativo de Kern Pharma Biologics y convertirlo en un centro de información científica de referencia para profesionales.
Mi rol en el proyecto
+ Arquitectura de la información
+ Diseño UI/UX